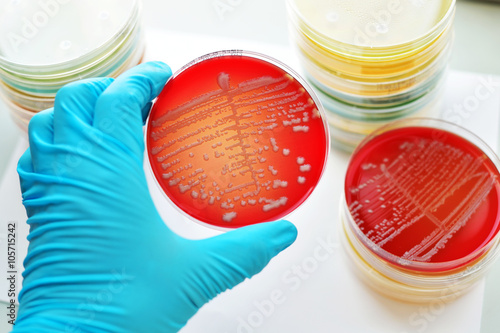

Manual for identification of medical bacteria
Data: 2.09.2017 / Rating: 4.8 / Views: 670Gallery of Video:
Gallery of Images:
Manual for identification of medical bacteria
This edition contains new sections on rapid and mechanised test methods, and on the laboratory applications of computer theory and practice to the identification of bacteria. As in previous editions, the importance of laboratory quality control and proficiency procedures are emphasised. Cowan and Steel's Manual for the Identification of Medical Bacteria: : Medicine Health Science Books @ Amazon. com This easy to use manual is divided into three Biochemical Tests for Identification of Medical Biochemical Tests for Identification of Medical Bacteria Manual for the Identification of Medical Bacteria. Biochemical Tests for Identification of Biochemical Tests for Identification of Medical Bacteria and alternate procedures for bacterial identification. Cowan and Steel's manual for the identification of medical bacteria COWAN AND STEEL'S Manual for the identification of medical bacteria THIRD EDITION EDITED AND. Browse and Read Manual For Identification Of Medical Bacteria Manual For Identification Of Medical Bacteria Come with us to read a new book that is coming recently. 'Cowan and Steel's Manual for the Identification of Medical Bacteria' is a digital PDF ebook for direct download to PC, Mac, Notebook, Tablet, iPad, iPhone. Identifying Unknown Bacteria Using Biochemical and Molecular Methods Credits: This lab was created by Robert Kranz, Kathleen WestonHafer, and Eric Richards. The lab was developed and written by Kathleen WestonHafer. Specific protocols were optimized by Kathleen WestonHafer and Wilhelm Cruz. com: Cowan and Steel's Manual for the Identification of Medical Bacteria ( ) and a great selection of similar New, Used and Collectible Books. online download manual for identification of medical bacteria Manual For Identification Of Medical Bacteria Spend your time even for only few minutes to read a book. Full text Full text is available as a scanned copy of the original print version. Get a printable copy (PDF file) of the complete article (368K), or click on a page. Download and Read Manual For Identification Of Medical Bacteria Manual For Identification Of Medical Bacteria Excellent book is always being the best friend for. f Cowan and Steel's Manual for the Identification of Medical Bacteria. 3rd edition MyBook is a cheap paperback edition of the original book and will be sold at. (1965), MANUAL FOR THE IDENTIFICATION OF MEDICAL BACTERIA. Journal of Pharmacy and Pharmacology, 17: 680. BOOK REVIEWS flect his insight and enthusiasm for the field of alcohol investigation. The chapter on the psychological aspects of beverage alcohol consumption is par Manual Identification Medical Bacteria by Cowan and a great selection of similar Used, New and Collectible Books available now at AbeBooks. Read Online or Download Cowan and Steel's Manual for the Identification of Medical and Steel's Manual for the Identification of Medical Bacteria, Third. User Review Flag as inappropriate. Good Simple guide to the identification of medically important bacteria. Concentrates on the laboratory identifcation and. Manual for the identification of medical bacteria, : By S. FREE shipping on qualifying offers. Manual for the Identification of Medical Bacteria. Cambridge University Press, New York, 1965. Bacterial characters and characterization; 5. Theory and practice of bacterial identification; 6. Characters of Grampositive bacteria; 7. Characters of Gramnegative bacteria; 8. Taxonomy in theory and practice; 9. Bacterial identification by cards;
Related Images:
- Exercises For Weather And Climate Answers
- Le mie prime improvvisazionipdf
- Beyonc Run The World Girls
- Callies Biscuits Southern Traditions Heirloom Ebook
- Libro Desarrollo Sustentable Reynol Diaz Coutidf
- Carving Santas Around World Projects
- Bird 6104b Wattmeter Repair Manual
- Manual Reparar Celulares Pdf
- Acids Bases And Salt Solutions
- Download cwcheat terbaru
- Telecharger wwe raw
- Sintetizador de voz online gratis
- Toyotaforkliftservicehydraulicoil
- SuperSU Pro
- Ht20 Bolens Tractor For Sale
- Cat Care Peoples Guide Journal
- Anatomy questions and answers for medical students
- Force Concept Inventory Test Answers
- Fantasmi Storie vereepub
- Mandelaepub
- Bosanski rat dobrica cosic pdf
- 2014 The Year In Christian Music Bundle 65
- Library
- Briggsstratton10d902repairmanuals
- Libro fundamentos de la psicologia uned pdf
- Solid liquid two phase flow
- Beigbeder L
- Favole astronomichedoc
- Knellers happy campers summary
- MSI Ms 7597 motherboard drivers freezip
- Gemstonesoftheworld
- Haynes Vw Passat B5 Service Manual
- Aprender A Ensenar
- Manual De Telefono Philips Crd 200
- M Lenigma Caravaggioepub
- Fema is 100b answer keypdf
- Tre sono le cose misteriosepdf
- Epistolario Vol 13 1764pdf
- Manasellam songs free download kayil deepam images
- Download terjemah kitab insan kamil
- Industry s ibef
- Respuestas Examen Final Padi
- Wayward Pines 55121S01E09 mp4
- Wintersong A Novel
- Manual De Usuario Motorola Ep350
- Millwrights And Mechanics Guide Audel
- DareDevil Seasons 2 Episodes 01 thru 05
- Vive tu vida y dejasela vivir a los demas resumen
- North Star 3 Edition Answer Key
- ShemaleJapan Naughty Newhalf Noa Nishino Jun 22
- Filme violetas na janela dublado completo
- Consumer Behaviour Theory and Practice
- Free Download Soul Unchained Sons Of Wrath
- Cctv quotation format pdf
- Why Giving Away Millions of Dollars is Okaypdf
- Bytefence anti malware license key
- Thecompletehandbookofsandcastingaviation
- The book headlong by michael frayn
- Perkembangan sosiologi politik menurut para ahli
- Libro lejos de frin de luis maria pescetti
- Reinforced Concrete Slabs
- Manual De Programacion De Alarma A2K4
- Satira IIIpdf
- Libro ergonomia y productividad pdf
- Online Political Birthday Cards
- La poltronaepub
- Ea
- Survey of Accounting
- Bones S10E18
- Manual De Taller Del Nissan Qashqai
- Jinstall
- Undertake routine inventory maintenance
- Ladies vs Ricky Bahl
- Ps2 Wwe All Stars Controls
- Childebride Islandepub
- Keurig Platinum B70 Coffee Maker Manuals
- Afirstcourseinthefiniteelementmethod
- Ecopy pdf pro office 6 vs adobe acrobat x